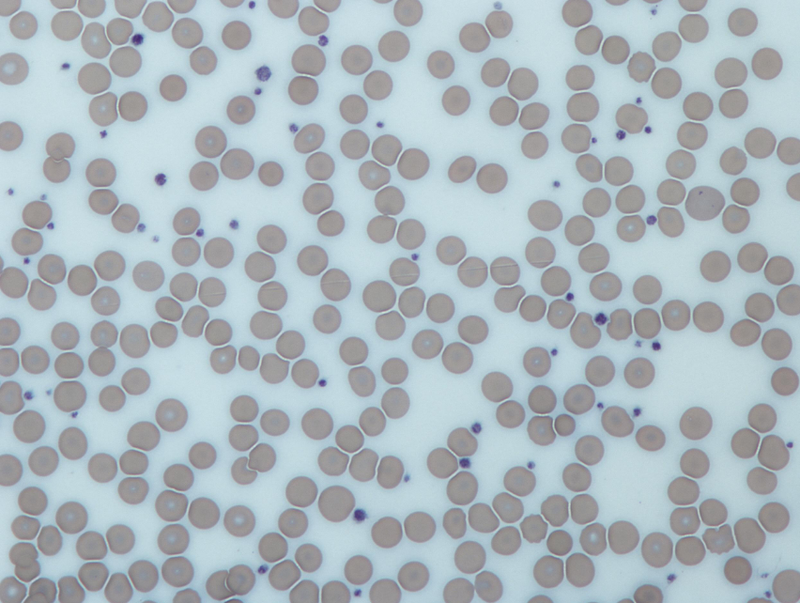
Tiểu cầu giảm bao nhiêu là nguy hiểm? Lưu ý gì để tránh biến chứng 1

Dược sĩ Đại học có nhiều năm kinh nghiệm trong việc tư vấn Dược phẩm và hỗ trợ giải đáp thắc mắc về Bệnh học. Hiện đang là giảng viên cho Dược sĩ tại Nhà thuốc Long Châu.
Tiểu cầu giảm bao nhiêu là nguy hiểm? Lưu ý gì để tránh biến chứng
09/11/2025
Mặc định
Lớn hơn
Tiểu cầu giữ vai trò quan trọng trong việc cầm máu. Nếu lượng tiểu giảm nhiều sẽ dẫn đến xuất huyết ở nhiều bộ phận, gây nhiều biến chứng nguy hiểm, có thể gây tử vong. Vậy tiểu cầu giảm bao nhiêu là nguy hiểm?
Giảm tiểu cầu là bệnh lý thường gặp. Nếu tình trạng giảm nhẹ, bệnh sẽ không gây nguy hiểm đến sức khỏe. Nhưng khi tiểu cầu giảm nghiêm trọng, bạn cần được điều trị sớm. Vậy tiểu cầu giảm bao nhiêu là nguy hiểm? Hãy tham khảo bài viết sau để tìm hiểu thông tin chi tiết về căn bệnh này nhé.
Thế nào được coi là giảm tiểu cầu?
Giảm tiểu cầu là gì?
Tiêu bản của tiểu cầu
Tiêu bản của tiểu cầuGiảm tiểu cầu là thuật ngữ mô tả tình trạng số lượng tiểu cầu dưới 150.000 tế bào/micro lít máu, đây là mức thấp hơn mức bình thường trong máu. Dù số lượng tiểu cầu giảm, chức năng đông máu và cầm máu của tiểu cầu vẫn được duy trì.
Khi số lượng tiểu cầu quá thấp sẽ làm chậm lại quá trình đông máu, có thể gây chảy máu tự phát bên ngoài, chảy máu dưới da hay chảy máu bên trong.
Triệu chứng giảm tiểu cầu
Để biết tiểu cầu giảm bao nhiêu là nguy hiểm, bạn nên tìm hiểu về triệu chứng của bệnh gồm:
Giảm tiểu cầu nhẹ: Người bệnh thường không có triệu chứng và chỉ tình cờ phát hiện khi đi khám bệnh và thực hiện xét nghiệm huyết đồ.
Giảm tiểu cầu nặng: Nếu tiểu cầu giảm dưới 20.000/micro lít máu có thể gây triệu chứng chảy máu không ngừng khi bị đứt tay, chân hoặc bị ra nhiều kinh nguyệt bất thường.
Tiểu cầu giảm dưới 10.000 - 20.000/micro lít máu có thể gây chảy máu tự phát với triệu chứng thường gặp là xuất huyết dưới da hoặc niêm mạc miệng, mũi, họng, niêm mạc ống tiêu hóa (chảy máu chân răng, chảy máu cam, có máu trong nước tiểu hoặc phân...).
Xuất hiện các nốt xuất huyết giảm tiểu cầu: Xuất hiện các vết xuất huyết nhỏ dưới da, màu đỏ với kích thước bằng đầu kim, phẳng, thường nằm ở hai cẳng chân. Đây là biểu hiện của xuất huyết ở niêm mạc hoặc các mao mạch dưới da.
Xuất hiện ban xuất huyết giảm tiểu cầu: Xuất hiện các nốt xuất huyết dưới da có đường kính trên 3mm. Nguyên nhân có thể do sự hội tụ của các nốt xuất huyết ở trên.
Nguyên nhân gây giảm tiểu cầu
Virus: Tủy xương có thể tạo ra ít tiểu cầu hơn khi cơ thể nhiễm virus quai bị, thủy đậu, rubella, HIV, viêm gan B, viêm gan C, virus Epstein Barr... Nhưng khi virus không còn trong cơ thể, tủy xương sẽ tiếp tục sản xuất tiểu cầu như bình thường;
Thuốc: Một số loại thuốc có thể tạo ra các kháng thể gây phá hủy tiểu cầu hoặc ức chế khả năng tạo tiểu cầu của cơ thể.
Bệnh lý ác tính: Số lượng tế bào tiểu cầu giảm do một số bệnh ung thư, tiêu biểu là bệnh bạch cầu.
Xuất huyết giảm tiểu cầu miễn dịch: Còn gọi là xuất huyết giảm tiểu cầu vô căn, là tình trạng rối loạn hệ thống miễn dịch, tạo ra các kháng thể phá hủy tiểu cầu.
Thiếu máu bất sản: Số lượng tiểu cầu giảm do tình trạng tủy xương không thể tạo ra các tế bào máu bình thường.
Hóa trị: Hồng cầu, bạch cầu và tiểu cầu đều bị tổn thương và bị giảm số lượng khi thực hiện hóa trị ung thư.
Gen di truyền: Một số bệnh lý làm giảm tiểu cầu thứ phát do đột biến gen.
Ban xuất huyết giảm tiểu cầu huyết khối: Tình trạng hình thành các cục máu nhỏ trong các mạch máu, phá hủy hồng cầu và tiểu cầu.
Lách to: Nếu lá lách to hơn thì nhiều tiểu cầu được lưu trữ trong lá lách sẽ bị mắc kẹt trong đó, gây giảm số lượng tiểu cầu trong máu.
Mang thai: Có thể gặp tình trạng giảm tế bào tiểu cầu ở khoảng 5% thai phụ hoặc là hậu quả của tiền sản giật.
Nguyên nhân khác: Uống rượu, mắc bệnh lupus ban đỏ hệ thống, thiếu vitamin B12 và axit folic, ghép tạng, truyền máu, tổn thương hoặc viêm mạch máu và các van tim, nhiễm trùng nặng...
 Giảm tiểu cầu nặng khiến người bệnh chảy máu không ngừng, khó cầm máu
Giảm tiểu cầu nặng khiến người bệnh chảy máu không ngừng, khó cầm máuTiểu cầu giảm bao nhiêu là nguy hiểm?
Tiểu cầu thường chỉ tồn tại được khoảng 7 - 10 ngày, sau đó sẽ bị loại bỏ. Số lượng tiểu cầu trung bình trong máu ở người khỏe mạnh là khoảng 150.000 - 450.000/micro lít máu.
Do đó, bạn cần lưu ý khi lượng tiểu cầu giảm nhiều bất thường. Vậy tiểu cầu giảm bao nhiêu là nguy hiểm? Mức nguy hiểm là khi tiểu cầu bị giảm số lượng xuống tới 50.000 tế bào/micro lít máu. Mức giảm nghiêm trọng là 10.000 - 20.000 tiểu cầu/micro lít máu. Khi bị giảm số lượng tiểu cầu, bác sĩ sẽ chỉ định cho bệnh nhân điều trị theo phương pháp phù hợp nhất tùy mức độ nặng - nhẹ của bệnh.
Khi số lượng tiểu cầu trong máu giảm mạnh sẽ gây tình trạng xuất huyết (chảy máu), dĩ nhiên khả năng đông máu và khả năng chống nhiễm trùng của người bệnh cũng giảm theo. Bệnh nhân có thể bị chảy máu chân răng, chảy máu cam, xuất huyết dưới da hoặc thậm chí xảy ra biến chứng xuất huyết não dẫn tới tử vong nhanh chóng.
Phương pháp điều trị giảm tiểu cầu
 Người bệnh nên vận động nhẹ nhàng tránh bị thương, chảy máu
Người bệnh nên vận động nhẹ nhàng tránh bị thương, chảy máuChọn cách điều trị giảm tiểu cầu phụ thuộc vào mức độ nghiêm trọng của các triệu chứng, nguyên nhân gây bệnh. Bạn cần lưu ý những điều sau:
- Bệnh nhân cần tránh sử dụng thuốc chống viêm không Steroid (đây là các loại thuốc làm giảm chức năng tiểu cầu) hoặc Aspirin.
- Trường hợp nhẹ hoặc không bị chảy máu: Bệnh nhân không cần điều trị. Cần kiểm tra lại số lượng tiểu cầu nhiều lần với bệnh nhân bị giảm tiểu cầu thứ phát sau nhiễm virus, để đảm bảo tiểu cầu trở về mức bình thường, kịp thời phát hiện các diễn biến bất thường.
- Ngừng sử dụng thuốc: Bệnh nhân cần tham khảo ý kiến bác sĩ xem có nên tiếp tục sử dụng loại thuốc làm giảm tiểu cầu không, có thể thay bằng loại thuốc khác không.
- Truyền tiểu cầu: Với các trường hợp giảm tiểu cầu thoáng qua khi hóa trị hoặc bị chảy máu lượng lớn kết hợp với giảm tế bào tiểu cầu, bác sĩ chỉ định truyền tiểu cầu.
- Sử dụng thuốc điều trị: Bệnh nhân bị giảm tiểu cầu miễn dịch có thể sử dụng thuốc như Steroid, Rituximab, Globulin, kháng sinh...
- Tách huyết tương: Phương pháp tách huyết tương được dùng cho bệnh nhân xuất huyết giảm tiểu cầu huyết khối.
- Cắt lách: Để cải thiện số lượng tiểu cầu, bác sĩ chỉ định cắt lách là phẫu thuật cắt bỏ một phần hoặc toàn bộ lách. Phương pháp này không được chỉ định cho trẻ em vì dễ tái phát, làm tăng nguy cơ nhiễm trùng về sau.
- Hạn chế uống rượu, hoạt động thể lực nhẹ nhàng. Với các bà bầu bị giảm tiểu cầu, cần tuân thủ nghiêm ngặt chỉ định của bác sĩ. Nên uống nước ép hoa quả, ăn cà chua, nước ép nha đam để bổ sung vitamin C, bổ sung vitamin B12 và axit folic...
Giảm tiểu cầu là bệnh lý nguy hiểm, nhất là khi bệnh chuyển sang thể nặng. Do đó, bạn cần đến bệnh viện để khám và điều trị ngay khi phát hiện các triệu chứng như trong bài viết đã nêu.
Quỳnh Trang
Nguồn tham khảo: Tổng hợp
Các bài viết liên quan
Huyết khối là gì? Các loại huyết khối thường gặp và những thông tin bạn cần biết
Tiểu cầu tăng bao nhiêu là nguy hiểm? Những lưu ý cho người bệnh tăng tiểu cầu
[Infographic] Enzyme Nattokinase hỗ trợ làm tan huyết khối như thế nào?
Quy trình hiến tiểu cầu được thực hiện như thế nào?
Xuất huyết dạ dày có nguy hiểm không? Cảnh báo biến chứng khẩn cấp
Giảm tiểu cầu có phải là ung thư máu? Dấu hiệu và cách điều trị
Tiểu cầu là gì? Đặc điểm, chức năng và cấu tạo tiểu cầu
Cơ chế giảm tiểu cầu trong sốt xuất huyết là gì? Hậu quả của giảm tiểu cầu khi bị sốt xuất huyết
Thuốc tăng tiểu cầu trong sốt xuất huyết: Công dụng và lưu ý khi sử dụng
Nguyên nhân gây giảm tiểu cầu thường gặp
:format(webp)/Option_1_2_2d9677e5fd.png)
:format(webp)/Option_1_1_2a84e0cd00.png)
:format(webp)/ds_my_huyen_780f9bef46.png)